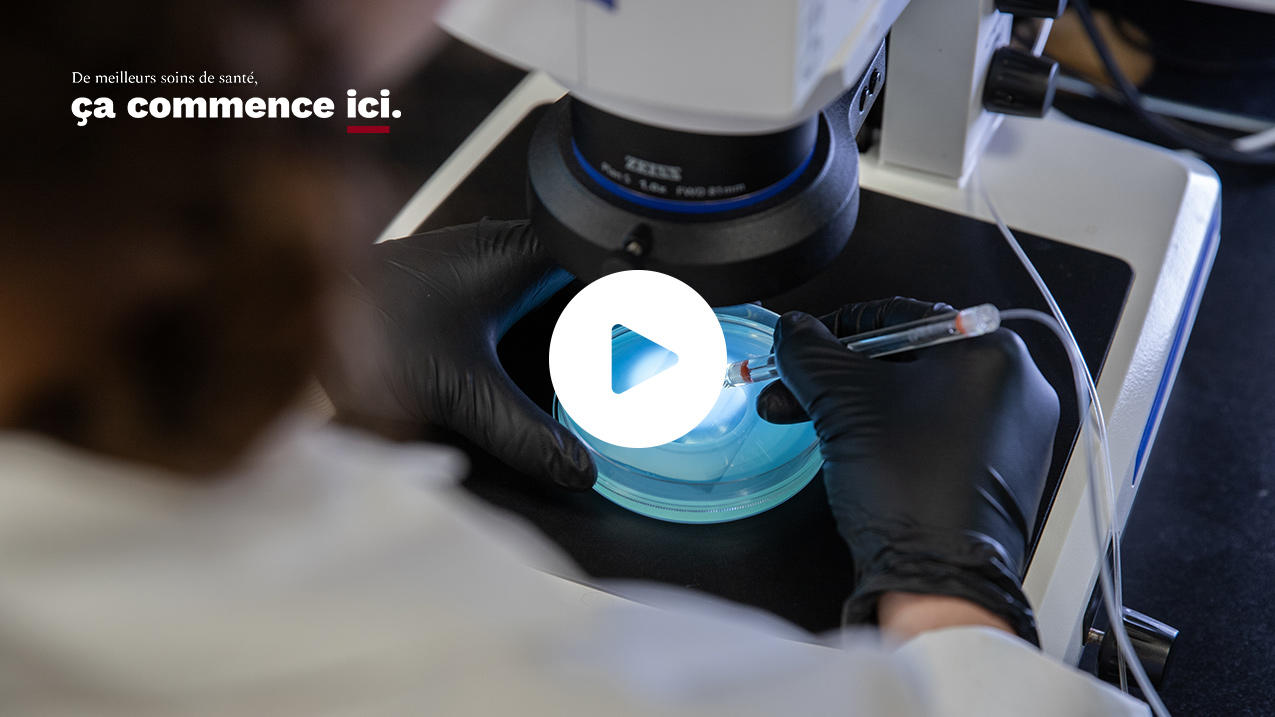
vue par dessus l'épaule d'une personne qui regarde un échantillon au microscope

« Dans le monde de l’oncologie pédiatrique, jusqu’aux trois quarts des patientes et patients participent à un essai clinique parce qu’il s’agit de la norme de soins. Les traitements d’aujourd’hui sont fondés sur les découvertes scientifiques d’hier », souligne le Dr Berman, aussi vice-président de la recherche au CHEO ainsi que PDG et directeur scientifique de l’Institut de recherche du CHEO.
De son bureau, il peut regarder de l’autre côté de la rue pour voir la construction du Centre de recherche médicale de pointe (CRMP) de l’Université d’Ottawa, qui ouvrira ses portes en 2026. « C’est un cercle vertueux, où les découvertes peuvent orienter les soins cliniques. Si les gens travaillent plus étroitement sur le même campus, ces avancées peuvent s’accélérer; et ce sont les patientes et patients d’ici qui seront les premiers à profiter des découvertes réalisées au CRMP », explique-t-il.

« [C]e sont les patientes et patients d’ici qui seront les premiers à profiter des découvertes réalisées au CRMP. »
Dr Jason Berman
— Professeur de pédiatrie à l’Université d’Ottawa
Construit au même endroit que la Faculté de médecine de l’Université d’Ottawa et près des hôpitaux locaux, cet immeuble de sept étages encouragera la collaboration en recherche entre des scientifiques de renommée mondiale et des cliniciennes et cliniciens qui prodiguent des soins dans notre système de santé public. Il représente le plus important investissement de l’histoire de l’Université et répond à une pénurie chronique de laboratoires nécessaires à l’amélioration des soins dont toutes les familles ont besoin.
Grâce à son vivier de talents et à son infrastructure de pointe, le CRMP catalysera les innovations qui peuvent révolutionner la prestation des soins dans la capitale nationale et ailleurs, et accroîtra la compétitivité de notre écosystème de recherche florissant sur la scène mondiale.
Selon le professeur Berman, il est essentiel de faire de la recherche là où l’on offre les soins. « Personne ne veut être soigné dans un hôpital qui n’a pas changé ses pratiques depuis dix ans s’il existe des données démontrant une meilleure façon de faire. Je crois que les gens s’en sont mieux rendu compte durant la pandémie. »
Un étage complet du CRMP deviendra un pôle d’innovation, où les équipes de recherche travailleront avec des partenaires du secteur privé pour incuber des entreprises en biotechnologies et accélérer la découverte de technologies et de traitements médicaux de prochaine génération. Les travaux scientifiques de pointe menés au CRMP changeront notre conception du monde à l’échelle moléculaire, et les partenariats stratégiques établis avec l’industrie et le gouvernement amélioreront des millions de vies en assurant de meilleures normes de soins.
La Dre Sharon Johnston juge essentiel de collaborer ainsi pour qu’Ottawa réalise son plein potentiel en tant que capitale de la biotechnologie. « On ne peut pas seulement compter sur les hôpitaux et la recherche financée par l’État. Quand l’industrie entre en contact avec les équipes de recherche dès le début, elle amène des ressources et des talents, ce qui fait naître des entreprises. Nous avons besoin de ces partenariats pour développer de nouveaux traitements et, ultimement, prodiguer les meilleurs soins qui soient », affirme-t-elle.
Médecin de famille, la Dre Johnston est aussi professeure agrégée à l’Université d’Ottawa ainsi que directrice scientifique et vice-présidente associée à l’Institut du Savoir Montfort, un centre de recherche situé dans le seul hôpital francophone de la région. Parmi ses domaines de recherche figurent le traitement et le rétablissement des victimes d’une commotion cérébrale.

« Le CRMP stimulera les découvertes qui mèneront à de meilleurs soins pour nos patientes et patients. »
Dre Sharon Johnston
— Professeure, uO; directrice scientifique et vice-présidente associée à l’Institut du Savoir Montfort
« On a besoin d’une communauté, d’une destination. C’est ce que sera le CRMP. Il faut que les équipes de recherche côtoient les médecins, le personnel infirmier, les techniciennes et techniciens en inhalothérapie – bref, les gens qui peuvent rendre la recherche plus pertinente en expliquant les signes et les symptômes qu’ils observent et les décisions de traitement qu’ils prennent. Les chercheuses et chercheurs pourraient alors prioriser l’étude d’un certain type de protéine selon ce qui est observé chez les personnes soignées », explique-t-elle.
Selon la Dre Johnston, cette collaboration recèle un grand potentiel, permettant d’accroître la taille des échantillons et de partager les ressources. « Il n’est jamais acceptable de sentir qu’on a atteint la limite, ajoute-t-elle. Le CRMP stimulera les découvertes qui mèneront à de meilleurs soins pour nos patientes et patients. »
Pour en savoir plus sur le CRMP et découvrir comment soutenir la recherche, l’innovation en soins de santé et le bien-être des patientes et patients au Canada, communiquez avec Jonathan Bodden, directeur exécutif au développement des affaires à l’Université d’Ottawa, à l’adresse jbodden@uOttawa.ca ou au 613-614-3571.